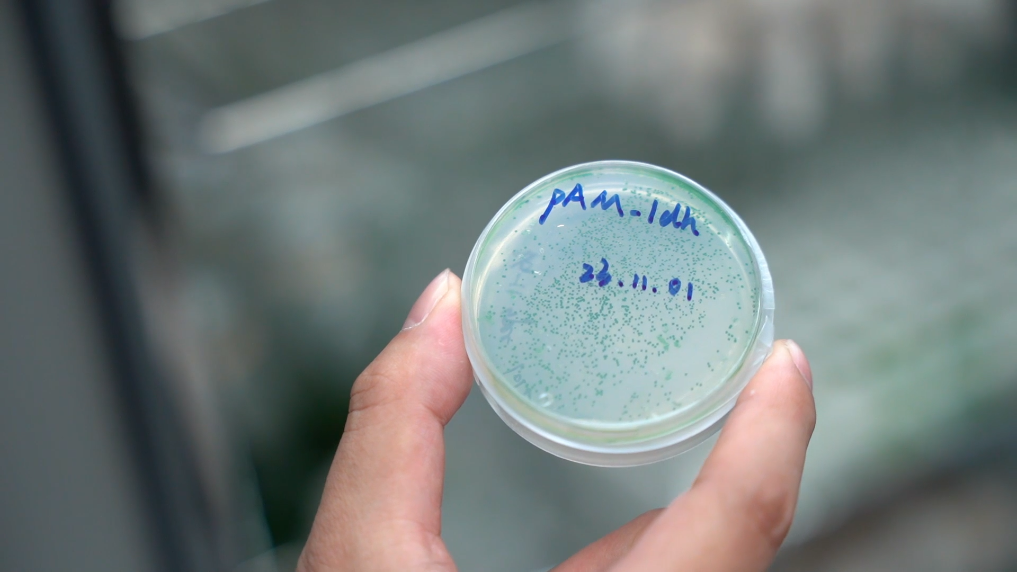

你见过“细胞工厂”吗?在这里,生产线上忙碌工作的是一颗颗通过显微镜才能看清楚的细胞,它们不吃饭也不睡觉,只要有阳光和空气,就能生产出一系列人们需要的高价值天然产物。

近日,记者走进这一神奇的“细胞工厂”,并通过上海交通大学生命科学技术学院特别研究员倪俊的讲述,了解被改造后的蓝藻细胞是如何从实验室走入工业生产。


记者:陈杰、董雪、许东远
新华社音视频部制作
【纠错】 【责任编辑:施歌】
你见过“细胞工厂”吗?在这里,生产线上忙碌工作的是一颗颗通过显微镜才能看清楚的细胞,它们不吃饭也不睡觉,只要有阳光和空气,就能生产出一系列人们需要的高价值天然产物。

近日,记者走进这一神奇的“细胞工厂”,并通过上海交通大学生命科学技术学院特别研究员倪俊的讲述,了解被改造后的蓝藻细胞是如何从实验室走入工业生产。

记者:陈杰、董雪、许东远
新华社音视频部制作